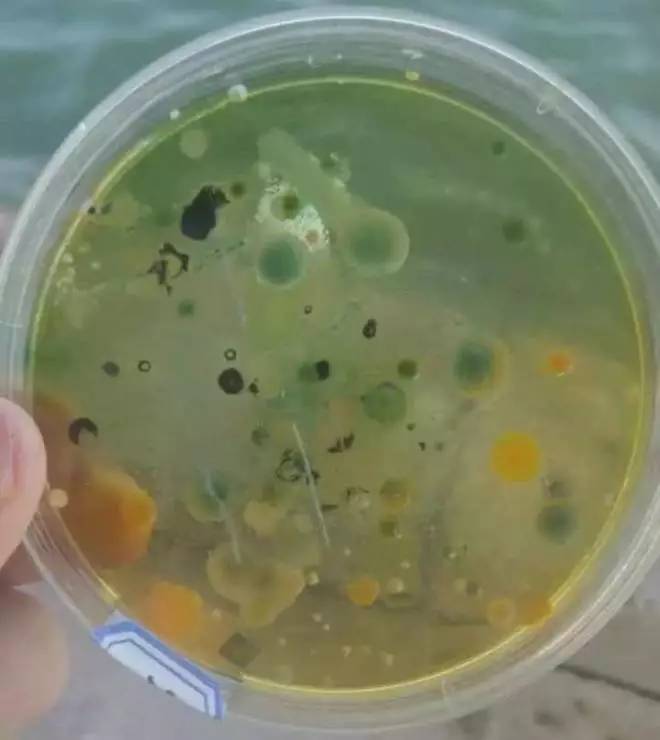
二氧化氯水产养殖使用注意事项,二氧化氯在水产养殖中的使用方法

几乎所有的养殖户朋友都在养殖过程中使用过二氧化氯,而二氧化氯所产生的好效果也是有目共睹的。
但你知道为什么水产养殖中更适合使用二氧化氯来进行消毒处理吗,跟着小润一起来学习一下吧~

二氧化氯的消毒机理
二氧化氯对细菌、病毒和孢子都有极强的破坏效果,但相关原理却十分复杂,虽然开展了很多研究,但到现在还是没有明确它的致命靶点,不过也有不少研究从不同层面上探讨了二氧化氯的效果原理。
NO.1 生物分子层面
二氧化氯可以和一些还原性的氨基酸(脯氨酸、组氨酸、半胱氨酸、酪氨酸、色氨酸和蛋氨酸)发生反应,从而让蛋白质失活。也有研究从氨基酸水平上解释了蛋白质失活的机制,证明了二氧化氯与蛋白质不发生涉及氯原子的取代反应。同时最新的研究也发现二氧化氯可以对遗传物质DNA产生损伤。

NO.2 微生物个体层面
常见的Cl2、NaClO等含氯消毒剂以及一些碘制对细菌的形态和结构均有比较明显的损伤,而二氧化氯对细菌的形态破坏并不明显,但也有研究指出,二氧化氯可以渗透并氧化定位在细胞表面的蛋白质上,导致细胞代谢紊乱,同时可以改变细胞膜的通透性,抑制呼吸,还能改变外膜蛋白质和脂类的构成,导致细胞内一些小分子物质(如钾离子、镁离子、ATP 等)会发生胞外泄漏。
二氧化氯与其他消毒剂对比
其实除了二氧化氯,养殖朋友们在水产养殖的过程中,或许还用过碘制剂、醛制剂、氯制剂、过氧化氢、过硫酸氢钾复合物粉等消毒产品。而在这些消毒剂中,二氧化氯与它们相比又拥有哪些独特之处呢?

·极低的杀菌浓度
二氧化氯具有一项十分独特的能力,即在极低浓度下就可以发挥效果,这是其他消毒剂所不具备的。对于液体CIO2的杀菌能力,0.5mg/L的二氧化氯在12h内对异养菌的杀死率保持在99%以上。二氧化氯含量高于0.6mg/L时,对金黄色葡萄球菌、大肠杆菌和白色念珠菌杀灭对数值高于3.00,即杀菌率高于99.9%;二氧化氯的含量为0.3mg/L时,仍能有效杀灭表皮葡萄球菌、停乳链球菌。
在研究二氧化氯对草鱼池塘环境异养菌数量变化时,全池泼洒二氧化氯,发现使用量达到3750g/hm²(水深平均1.4米)时,即使用量达到0.27mg/L时,即可降低水体和底泥中有的有害菌数量。

·其他对比
另外一方面,我们在综合杀菌力、对环境的友好、稳定性、腐蚀性以及刺激性,将二氧化氯与其他消毒做一个更详细的对比,如下表:

<二氧化氯与其他消毒剂的对比>
二氧化氯作用效果

二氧化氯在水产养殖上的杀菌研究也是相当多的。
【1】艾晓辉等人(2002年)测定了二氧化氯对 七种水产常见致病菌 (鱼害粘球菌 、肠型点状产气单胞菌 、荧光极毛杆菌 、点状产气单胞菌 、嗜水气单胞菌9120 、鳗弧菌、嗜水气单胞菌T3)的最低有效杀菌浓度,分别为 1.56、12.50、25.00、6.25、3.12、12.50、3.12μg /ml 。
【2】陈超然等人(2003年)使用4种消毒剂在试管内对几种水产动物致病菌做了最小杀菌浓度对比。试验结果显示 二氧化氯对柱状嗜纤维菌最小杀菌浓度是最低的 ,为0.78-1.56mg/L,是漂*粉白**的1/16;二氧化氯对嗜水气单胞菌最小杀菌浓度也是最低的,为0.78-1.56mg/L,为漂*粉白**的1/16;对鳗弧菌的最小杀菌浓度二氧化氯也是最低的,为1.56-3.13mg/L,为漂*粉白**的1/8;对迟缓爱德华氏菌的最小杀菌浓度也是最低的,为1.56mg/L,最低为漂*粉白**的1/16 。

【3】陈超然等人(2011年)使用3种消毒剂(二氧化氯、三氯异氰尿酸、漂*粉白**)针对南美白对虾浸泡,最终检测对虾鳃部细菌变化, 结果是当二氧化氯的浓度达到0.1 mg/L时,对虾鳃部上附着菌的清除率可以达到70%以上 ,而达到同等清除率,三氯异氰尿酸需要0.5mg/L,漂*粉白**需要1mg/L 。
二氧化氯的其他作用
对水体其他指标的影响
溶解氧: 二氧化氯使用到养殖水体后,对于水体的很多指标都会产生一些影响。在溶氧方面,不管是淡水还是海水,二氧化氯都可以明显提高水体的溶解氧,溶氧的增加量可以达到5.8%-22.7%,同时研究显示低浓度组(0.5×10-3mol/L -2×10-3mol/L)的溶解氧在6h内呈上升趋势,然后开始下降,而高浓度组(3×10-3mol/L)则在51小时内仍能保持较高的溶氧值。

氨氮、亚硝酸盐: 二氧化氯可以降低水中的氨氮值,降低比率达到19.4%-38.5%。研究指出,使用二氧化氯可以降低水中的氨氮和亚硝酸盐含量,最大降低幅度可以达到58.9%、25%。二氧化氯相比于漂*粉白**、漂粉精和强氯精,降低亚硝酸盐和硝酸盐含量的效果更强,30 分钟时硝酸盐和亚硝酸盐的消除率高达99%、100%。而且二氧化氯因为其氧化性,所以其对一些重金属离子(Fe2+、Mn2+)、硫化物(二价硫离子S2-、硫化氢H2S、氢硫化物HS-)都具有一定的去除效果。
消毒副产物
目前水产养殖所使用的稳定性二氧化氯粉剂产品,实际上由亚氯酸钠、酸及稳定剂组成,亚氯酸钠和酸见水后发生反应,会生成二氧化氯,在反应过程中会生成具有一定毒性的副产物亚氯酸钠。对于亚氯酸钠,美国化学品制造协会(USCMA)规定饮用水中 NaClO2 的最大污染水平(MCL)为 1.0mg/L,最大污染水平目标值(MCLG)为 0.8mg/L,我国规定为 0.7mg/L 。很明显, 水产养殖实际使用二氧化氯的用量是绝不可能达到这个水平的。
总结
二氧化氯作为一种绿色消毒剂,具有用量少、快速见效、高效广谱、温和安全等优点,而且其使用成本较低,因而受到广大养殖朋友的青睐。但市场上二氧化氯鱼目混珠,选择使用正品二氧化氯才能使其在水产养殖领域真正的发挥作用~